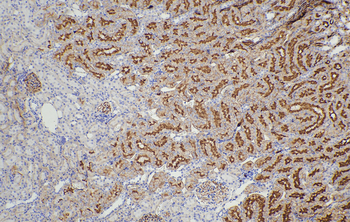
Multi-rAb Polymer HRP-Goat Anti-Mouse Recombinant Secondary Antibody (H+L)

You have no items in your shopping cart.
DOT, ELISA, WB
Mouse
Goat
Recombinant
HRP
1 ml, 200 μlFC, IF
Mouse
Goat
Recombinant
CoraLite® Plus 488
1 ml, 200 μlIHC
Mouse
Goat
Recombinant
HRP
10 x 5 ml, 3 x 5 ml, 5 mlFC, IF
Mouse
Goat
Recombinant
CoraLite® Plus 594
1 ml, 200 μlFC, IF
Mouse
Goat
Recombinant
CoraLite® Plus 555
1 ml, 200 μlFC, IF
Mouse
Goat
Recombinant
CoraLite® Plus 647
1 ml, 200 μl- Goat Anti-Mouse IgM, HRP conjugated [orb868949]
ELISA, IHC-Fr, IHC-P, WB
Mouse
Goat
Polyclonal
HRP
100 μl, 1 ml - Goat Anti-Mouse IgM [orb869150]
ELISA, IF, IHC-Fr, IHC-P, WB
Mouse
Goat
Polyclonal
Unconjugated
- Rabbit Anti-Mouse IgM, FITC conjugated [orb868294]Featured

FC, ICC, IF
Mouse
Rabbit
Polyclonal
FITC
100 μl, 1 ml